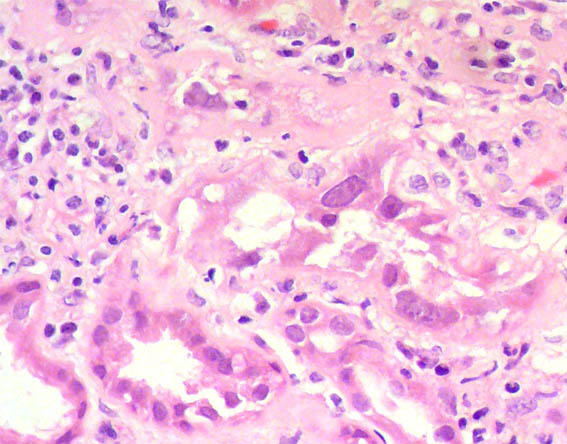

|
|
CASE
128 (October 2016)
Clinical information
The patient is a 39-year-old man with end-stage renal disease of unknown cause. He was kidney transplanted from cadaveric donor two years before. In a control, two months ago, serum creatinine (SCr) was 1.2 mg/dL. Now he is evaluated by presenting diarrheal disease, weakness and malaise. SCr is 2.1 mg/dL. After two days of proper hydration, the SCr continues equal, so a renal biopsy was done, see the images.

Figure 1. H&E, X100.

Figure 2. Masson's trichrome stain, X100.

Figure 3. H&E, X400.

Figure 4. H&E, X400.
Figure 5. H&E, X400.

Figure 6. Methenamine-silver stain, X100.

Figure 7. H&E, X400.

Figure 8. Methenamine-silver stain, X400.

Figure 9. Immunohistochemistry for SV40, X400.

Figure 10. Immunohistochemistry for SV40, X200.
Direct immunofluorescence for IgA, IgG, IgM, C3, C1q, kappa and lambda: Negative.
What is your diagnosis?
What is the cause of the crescent evidenced in a glomerulus?
See
diagnosis and discussion
[Top]
|
|